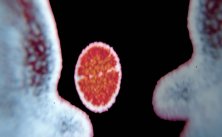

Silvia Costeloe negli studi di La6 Tv
Silvia Costeloe negli studi di La6 Tv"Genesi. Già di chi e di che cosa? Di luce, cioè più esattamente del bello, del buono dell'armonico: la genesi dell'intero, dell'interezza. (…) Racconti che non sono fiabe, testi che non sono magia, parole che non evadono le domande ma le pongono, passaggi logici e misteriosi al tempo stesso, simboli da levigare perchè brillino della loro luce propria… Mi sembra che un po' così si possa esprimere il sentore che nasce dalle pagine del libro della Genesi relativa alla creazione, cioè i primi due capitoli".
Ad introdurre con queste parole il lavoro firmato a quattro mani da Silvia Costeloe e Antonio Bandirali, intitolato "Genesi. I giorni della Creazione", è Don Luca Violoni. Un lavoro di video, fotografia e musica che non pretende di spiegare didascalicamente la Genesi del mondo e dell'Uomo, che non cerca la definizione matematica delle cose ma una polifonia di verità, che non vuole risposte escatologiche, ma pone, piuttosto, delle domande.
A presentare questo inedito assemblaggio di musiche e di immagini fotografiche in movimento è Silvia Costeloe che, per ragioni di studio e, ora, di lavoro, ha a che fare quotidianamente con registrazioni digitali e montaggi di post-produzione. "Il video, contenuto nel DVD, anima e manipola, in un certo senso, le immagini di Antonio Bandirali. Immagini astratte che mettono a tema i nuclei fondamentali e fondanti del racconto biblico: quello della vita e della luce", spiega la Costeloe che, oltre ad aver curato il mixaggio, ha composto tutti i brani musicali che accompagnano il "primordiale viaggio" nei giorni della Creazione.
"E' interessare poter constatare – precisa la Costeloe negli studi di La6 Tv – quanto un testo così denso e complesso ponga domande estremamente attuali, che riguardano l'essenza umana, la natura del mondo e delle cose, il destino degli esseri viventi". Sono domande di senso, quì accennate, quasi bisbigliate con forme in
Silvia Costeloe negli studi di La6 Tv
Silvia Costeloe negli studi di La6 Tvmovimento, colori, luci e musiche. Il volto umano è appena tracciato e alluso, la creazione è scandita come un processo logico e consequenziale. Compare, in tutta la sua drammatica evidenza, la responsabilità cui l'essere umano, nel momento fondativo del mondo, è chiamato.
Chiamare il mondo – Non esiste forse compito più alto e responsabilizzante che quello di dare un nome alle cose del mondo: "Allora il Signore Dio plasmò dal suolo ogni sorta di bestie selvatiche e tutti gli uccelli del cielo e li condusse all'uomo, per vedere come li avrebbe chiamati: in qualunque modo l'uomo avesse chiamato ognuno degli esseri viventi, quello doveva essere il suo nome. Così l'uomo impose nomi a tutto il bestiame, a tutti gli uccelli del cielo e a tutte le bestie selvatiche". Il nome esprime l'identità e qualche volta la sostanza di un individuo e all'uomo è stato affidato il compito immenso di "marchiare con le parole", con un proprio linguaggio, con la propria voce si potrebbe dire, tutto il creato.










